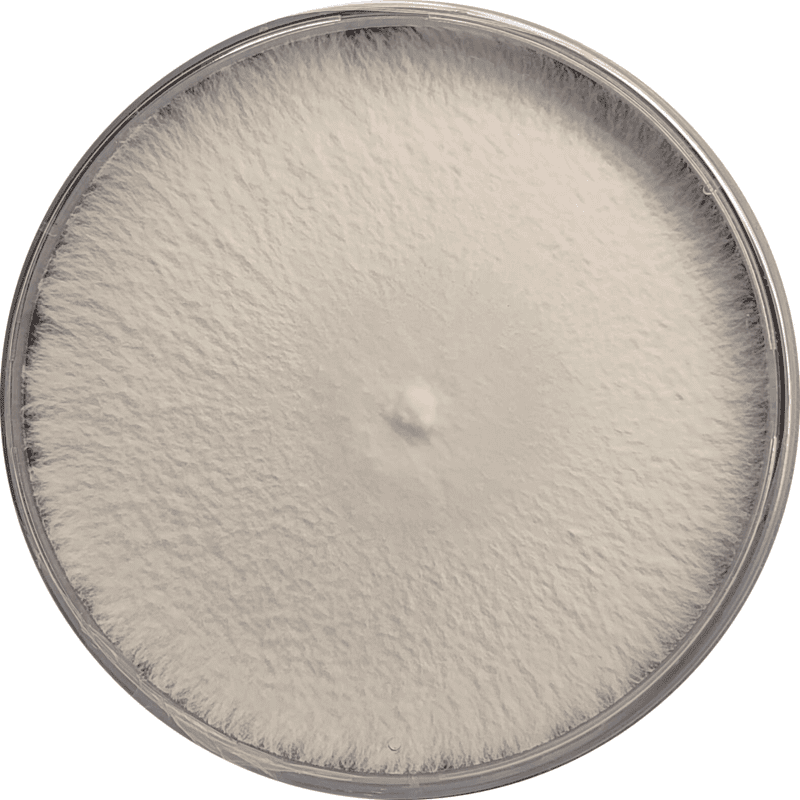

Ganoderma lucidum (Reishi Mushroom) – Pure Culture Plate
The Reishi Mushroom (Ganoderma lucidum) is one of the most revered medicinal mushrooms in traditional and modern herbal medicine. It is prized for its glossy reddish-brown fruiting body and its wide range of therapeutic compounds, including triterpenes, polysaccharides, and antioxidants that promote longevity, immune balance, and overall wellness.
Our pure culture plates are aseptically prepared under controlled laboratory conditions to ensure contamination-free, genetically pure mycelium. The strain exhibits robust growth and adaptability to a range of hardwood-based substrates, making it suitable for both commercial spawn labs and research programs.
Ideal for:
Medicinal mushroom cultivation and extract production
Research on bioactive compounds and strain improvement
Spawn and fruiting block production on logs or supplemented sawdust
Key Features:
Authentic Ganoderma lucidum strain with glossy, red-brown fruiting bodies
Rich in bioactive compounds like beta-glucans and triterpenes
Excellent adaptability to various substrates and environmental conditions
Long-lasting mycelial vigor and strong disease resistance
Valued for its immune-boosting and antioxidant properties
🍄 Proudly prepared and stored at Agripie Agrosystem LLP, India 🇮🇳

 |
|  |
| 
